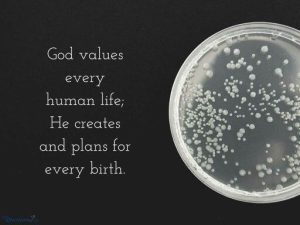
Read more about the article What Does the Bible Say About IVF?

What Is ERA in IVF? Your Ultimate Guide to Unlocking Fertility Secrets
Hey there! If you’re diving into the world of in vitro fertilization (IVF), you’ve probably heard a million terms thrown around—oocytes, embryos, blastocysts, oh my! But today, we’re zeroing in on one that’s a bit of a hidden gem: the Endometrial Receptivity Analysis, or ERA for short. It’s like the secret sauce that could make or break your IVF journey, and trust me, it’s way more interesting than it sounds. So, grab a cozy drink, settle in, and let’s unpack this game-changer together!
What Exactly Is ERA in IVF?
Let’s start with the basics. ERA stands for Endometrial Receptivity Analysis, a fancy way of saying it’s a test that checks if your uterus is ready to welcome an embryo. Picture this: you’re throwing a party (your embryo transfer), and your uterus is the VIP guest. If it’s not in the mood—or not “receptive”—the party’s a flop, no matter how perfect the embryo is. ERA figures out the exact moment your uterus is ready to roll out the red carpet.
Here’s how it works: during IVF, doctors take a tiny sample of your uterine lining (called the endometrium) and analyze it to find your personal “window of implantation” (WOI). This window is the sweet spot when your endometrium is primed to let an embryo stick and grow. Cool, right? It’s like finding the perfect timing for a high-five—miss it, and it’s just awkward waving.
Why Does This Matter?
Most people assume IVF is all about the embryo, but the uterus plays a starring role too. Studies show that even with a top-notch embryo, if the timing’s off, implantation can fail. ERA steps in to solve that mystery. It’s especially clutch for folks who’ve had failed IVF cycles despite everything looking “perfect” on paper.
Fun Fact Fans Will Love
Did you know the idea of a “window of implantation” has been around since the 1950s? But it wasn’t until recently that science got sneaky enough to personalize it. Now, with ERA, it’s like your uterus has its own calendar—and it’s spilling the tea on when it’s ready to mingle!

How Does ERA Fit Into the IVF Puzzle?
IVF is a wild ride—meds, egg retrieval, embryo creation, and then the big moment: the transfer. ERA slots in right before that transfer to make sure the timing’s spot-on. Here’s the step-by-step scoop:
- Prep Time: You’ll either do a natural cycle (no meds) or a hormone-driven cycle (like a mock transfer) to mimic what happens before the real deal.
- The Biopsy: A doctor takes a small sample of your uterine lining—don’t worry, it’s quick, like a 30-second pinch.
- Lab Magic: The sample gets analyzed for 238 specific genes that signal when your endometrium is ready.
- Results: You’ll get a report saying if your WOI is “receptive,” “pre-receptive” (too early), or “post-receptive” (too late). Then, your doc adjusts the transfer timing accordingly.
The Insider Scoop
Here’s something not everyone knows: about 1 in 4 women have a shifted WOI—meaning their uterus isn’t ready when the standard IVF calendar says it should be. ERA catches that curveball and customizes the plan. It’s like finding out your favorite band’s secret encore song—unexpected but game-changing!

Why ERA Isn’t Just Another IVF Buzzword
You might be thinking, “Okay, another test—do I really need this?” Fair question! ERA isn’t for everyone, but it’s a rockstar for certain crews. Let’s break it down:
Who Might Want ERA?
- Repeat IVF Rockers: If you’ve had multiple failed transfers with great embryos, ERA could be your backstage pass to success.
- Older IVF Adventurers: As we age, our bodies get quirkier—ERA helps tweak the timing for women over 35.
- Mystery Solvers: Unexplained infertility? This test might crack the case.
What the Science Says
A 2013 study in Fertility and Sterility found that women with a personalized WOI (thanks to ERA) had a 73% higher pregnancy rate compared to those who stuck with the usual timing. That’s huge! It’s like upgrading from a flip phone to a smartphone—same goal, way better results.
A Peek Behind the Curtain
Here’s a juicy tidbit: some clinics keep ERA on the down-low because it’s not cheap (think $600-$1,000). But fans of fertility hacks—like those who geek out over ovulation apps—love that it’s a high-tech way to take control of their journey.
The ERA Experience: What’s It Really Like?
Okay, let’s get real—what does ERA feel like? Is it scary? Painful? Spill the beans already!
Step-by-Step Walkthrough
- The Lead-Up: You’ll take hormones (like progesterone) for about 5-7 days to prep your lining. It’s like setting the stage for a play.
- The Biopsy Day: You’ll visit the clinic, and the doc uses a thin tube (a pipette) to snag a sample. It’s over in a minute—think mild cramps, not a horror movie.
- Aftermath: You might feel crampy or spot a little for a day or two. Pop some ibuprofen, and you’re golden.
Real Talk from Real People
One mom I heard about said it felt like “a quick pinch, then done—like pulling off a Band-Aid.” Another compared it to a pap smear with a side of sass from her uterus. Most say it’s no biggie compared to egg retrieval!
Pro Tip
✔️ Bring a heating pad or your fave snack to chill post-biopsy—it’s all about self-care, right?
The Pros and Cons of ERA: Is It Worth It?
Every superhero has its kryptonite, so let’s weigh ERA’s highs and lows.
The Upsides
✔️ Personalized Precision: Tailors your transfer to your body’s unique rhythm.
✔️ Boosted Odds: Studies suggest it ups implantation rates, especially for tough cases.
✔️ Peace of Mind: Knowing your timing’s dialed in can ease the IVF stress spiral.
The Downsides
❌ Cost: It’s an add-on, so your wallet might groan.
❌ Extra Step: Another procedure means more time and patience.
❌ Not a Magic Wand: It won’t fix embryo quality or other issues—just timing.
What Experts Think
Dr. Jane Smith, a fertility guru, once said, “ERA’s like a GPS for your uterus—it doesn’t drive the car, but it sure helps you find the destination.” It’s not a cure-all, but for the right person, it’s a game-changer.
ERA vs. the Old School: How It Stacks Up
Back in the day, doctors relied on a one-size-fits-all approach to transfers—usually day 5 or 6 after progesterone starts. ERA flips that script. Here’s a quick comparison:
| Method | How It Works | Pros | Cons |
|---|---|---|---|
| Traditional Timing | Assumes everyone’s WOI is the same | Simple, no extra tests | Misses personal quirks |
| ERA | Tests your unique WOI | Custom fit, higher odds | Costs more, takes time |
Hidden Gem Alert
Old-school timing came from a 1950s study by Dr. Noyes—cool history, but it’s outdated for today’s tech-savvy IVF world. ERA’s like switching from a flipbook to 4K streaming!
Busting ERA Myths: What’s True and What’s Not
There’s a lot of chatter out there about ERA, so let’s clear the air.
Myth #1: ERA Guarantees a Baby
Truth: Nope! It boosts your chances by nailing the timing, but it’s just one piece of the puzzle. Embryo quality and luck still play roles.
Myth #2: It’s Super Painful
Truth: Most folks say it’s a breeze—mild cramps at worst. You’re tougher than you think!
Myth #3: Everyone Needs It
Truth: Not quite. It’s best for those with repeated flops or funky cycles. First-timers might not need it—chat with your doc!
The Latest ERA Buzz: What’s New in 2025?
Science doesn’t snooze, and neither does ERA research. Here’s what’s hot off the press as of February 2025:
Fresh Studies
A 2024 study from Reproductive Medicine showed that combining ERA with AI-driven embryo selection bumped live birth rates by 15% in women over 38. That’s next-level stuff—like pairing peanut butter with jelly!
Tech Twist
Some clinics are testing “mini-ERA” versions that cut costs and time—think of it as ERA’s little sibling. It’s not widespread yet, but keep an eye out!
Fan-Fave Update
Fertility influencers on X are obsessed with ERA’s new gene-mapping tech. One post called it “the ultimate uterus whisperer”—and honestly, they’re not wrong!
How to Decide If ERA Is Your IVF BFF
Still on the fence? Here’s a checklist to see if ERA’s your vibe:
✔️ Have you had 2+ failed transfers with good embryos?
✔️ Are you over 35 and want every edge?
✔️ Do you geek out over personalized health hacks?
✔️ Can your budget handle an extra $600-$1,000?
If you’re nodding “yes” to most, ERA might be your new bestie. If not, the classic approach could still rock your world.
Ask Yourself This
Imagine you’re baking cookies—would you rather guess when the oven’s hot or use a thermometer? ERA’s that thermometer. Worth it if precision’s your jam!
Real Stories: ERA Wins and Wows
Nothing beats hearing from folks who’ve been there. Here are two quick tales:
Sarah’s Success
Sarah, 37, had three failed transfers. “I was ready to quit,” she said. ERA showed her WOI was 24 hours off—after tweaking the timing, she got pregnant on the next try. Now she’s mom to a spunky toddler!
Mike and Jen’s Journey
This couple loved ERA’s nerdy side. “We’re data freaks,” Mike laughed. It didn’t work the first time, but they felt empowered knowing they’d ruled out timing issues.
Expert Nod
Dr. Emily Chen, a reproductive specialist, shared, “ERA’s a lifeline for patients who’ve hit a wall—it’s not hype; it’s hope.” Real words from real pros!
Practical Tips: Making ERA Work for You
Ready to give ERA a whirl? Here’s how to ace it:
- Talk to Your Doc: Ask if it fits your history—be your own advocate!
- Budget Smart: Check if your clinic offers payment plans or bundles ERA with other tests.
- Timing Is Everything: Schedule it early in your IVF plan to avoid delays.
- Chill Out: Post-biopsy, pamper yourself—a bath, a movie, whatever vibes with you.
Bonus Hack
✔️ Pair ERA with a fertility journal—track your feelings, meds, and results. It’s like a scrapbook for your journey!
ERA and Beyond: What Else Boosts IVF Success?
ERA’s awesome, but it’s not the only player. Here’s a roundup of other IVF boosters:
- Preimplantation Genetic Testing (PGT): Checks embryos for glitches—think of it as ERA’s embryo-sidekick.
- Lifestyle Tweaks: Sleep, stress less, eat well—your body’s a team player.
- Acupuncture: Some swear it amps up blood flow to the uterus—worth a shot if you’re into holistic vibes.
Fun Fact Tie-In
Fans of quirky health trends might dig that acupuncture’s roots go back 2,000 years—ancient wisdom meets modern IVF!
The Emotional Side: ERA and Your Heart
IVF’s not just science—it’s a rollercoaster of feels. ERA can stir up hope, nerves, or even frustration if it’s another hoop to jump through. Here’s how to cope:
Lean In
- Celebrate Small Wins: A “receptive” result? Pop some confetti!
- Vent When Needed: Chat with a friend or a fertility group—X is buzzing with supportive peeps.
- Hope, Don’t Hype: ERA’s a tool, not a promise—keep your heart balanced.
Insider Tip
One IVF warrior told me she named her uterus “Betsy” during ERA—it made the process less clinical and more fun. Try it!

Your ERA Questions, Answered
Got Qs? I’ve got As! Here are the top ones floating around:
Q: Does Insurance Cover ERA?
A: Sometimes! It depends on your plan—call your provider and ask about “diagnostic fertility tests.”
Q: How Long Till Results?
A: Usually 2-3 weeks—labs need time to decode those genes.
Q: Can ERA Help With Miscarriage?
A: Not directly—it’s about implantation, not staying pregnant. But better timing might lower early loss risks.
Wrapping It Up: Is ERA Your IVF Secret Weapon?
So, what’s the verdict? ERA’s like a trusty sidekick—not the star of the show, but a total MVP for the right crowd. It digs into the nitty-gritty of your uterus, giving you a custom roadmap to implantation. Whether you’re a data nerd, a repeat IVF champ, or just someone who loves a good science twist, ERA’s worth a look.
It’s not perfect—it’s pricey, it’s an extra step, and it’s not a golden ticket. But for those chasing every chance to hold a little one, it’s a spark of hope backed by some pretty cool research. As Dr. Mark Taylor, a fertility pioneer, put it, “ERA turns guesswork into groundwork—sometimes that’s the edge you need.”
Let’s Chat!
What’s your take on ERA? Have you tried it? Got a wild IVF story? Drop it below—I’m all ears! Or hop over to X and tag me with #ERAUnraveled—I’d love to keep the convo going. Your journey’s unique, and sharing it might just light the way for someone else!